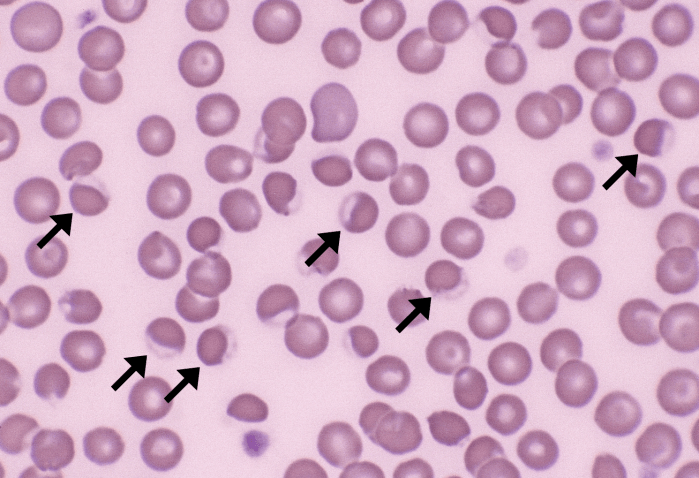
Eccentrocytes 1 (Canine - Onion Tox) ARROWS
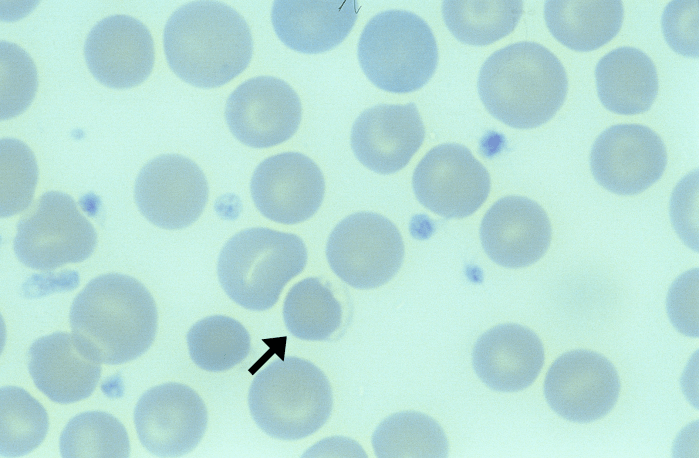
Eccentrocytes 2 (Canine) ARROWS

Eccentrocytes
Morphology: red blood cells with a clear crescent-shaped area along one side of the periphery. Formed by the fusion of two layers of oxidized cell membrane with no hemoglobin in between.
Commonly seen with: Heinz bodies
Clinical relevance: indicates oxidant injury to red blood cells. Oxidant injury may result from certain drugs (propofol and acetaminophen in cats) or from toxins (onions, red maple leaves in horses, zinc in dogs, copper in sheep, anticoagulant rodenticide in dogs, and skunk musk in dogs). Oxidant injury may also result from certain diseases (lymphoma and diabetes mellitus in dogs).

What would be the difference (morphologically speaking) between Eccenthrocytes red blood cells and Blister Cells? How can you differentiate visually between these two?
LikeLike
Thanks for your question! Eccentrocytes on a blood smear have a completely clear/non-staining, crescent shaped area along one edge of the cell whereas blister cells have a small, clear circle at the cell periphery that is still surrounded by a rim of hemoglobin; the latter is often compared to a hole-punch in a piece of paper.
LikeLike